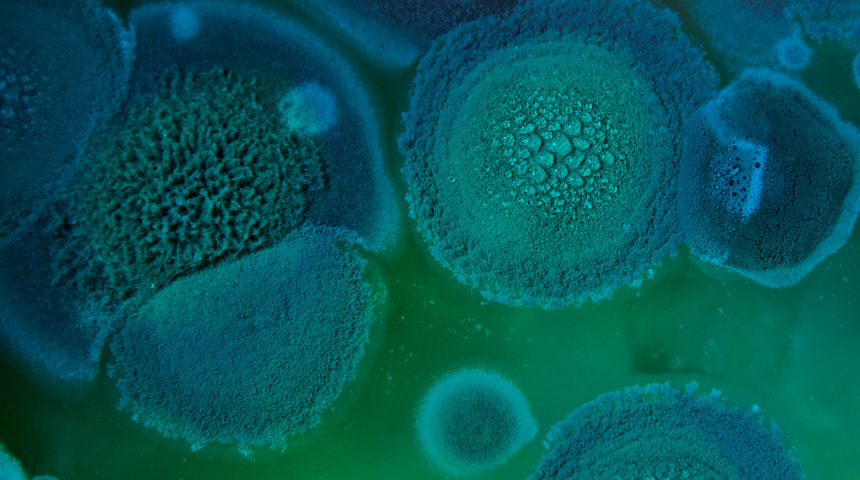
Bilim insanları alarma geçti! Ölümcül mantar milyonlarca insanı öldürebilir! Akıllara o popüler dizi geldi...

0% Faizli Fırsat!

Faiz Oranı
%0
Vade
3 Ay
Toplam Tutar
100.000 TL
Manchester Üniversitesi'nde yapılan araştırmaya göre insanlara bulaştığında akciğer ve solunum problemlerine yol açabilen bir küf türü olan Aspergillus'un, artan sıcaklıklar nedeniyle Avrupa, Asya ve Amerika'nın daha kuzeydeki ülkelerine yayılmasıyla yılda milyonlarca insanı enfekte edebilecek.

Çalışmanın ortak yazarı olan Manchester Üniversitesi'ndeki Wellcome Trust araştırma görevlisi Norman van Rhijn, evlerin iç kısımları da dahil olmak üzere çok çeşitli ortamlarda gelişen mantar patojenlerinin artışı konusunda dünyanın bir dönüm noktasına yaklaştığını söyledi.

Rhijn, mantar enfeksiyonlarının her yıl dünya çapında milyonlarca ölüme neden olacağını söyledi. Bu ölümcül mantar, astım , kistik fibroz veya zayıf bağışıklık sistemi gibi rahatsızlıkları olanlar için özellikle tehdit edici olabilir.

Mantar araştırmaları, Aspergillus fumigatus'un 2100 yılına kadar dünyanın yoğun fosil yakıt kullanımı sonucu ek olarak yüzde 77'lik bir bölgeye yayılabileceğini Avrupa'da dokuz milyon insanın enfeksiyona maruz kalabileceğini gösteriyor.
onlymyhealth.com'da yer alan bilgiye göre bu öldürücü mantar akıllara The Last of Us isimli diziyi getirdi. Dizide zihin kontrol eden bir mantarın neden olduğu bir zombi kıyametinin korkutucu hikayesi işleniyordu. Cordyceps adlı mutasyona uğramış bir mantar insanları enfekte ederek onları saldırgan, zombi benzeri yaratıklara dönüştürüyor.
